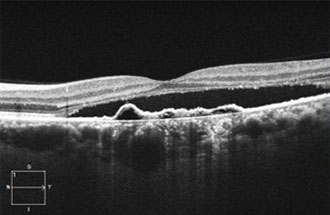
octa
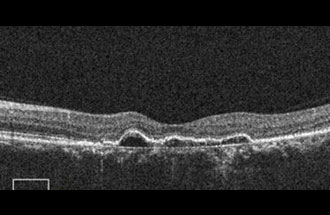
octa
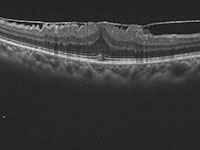
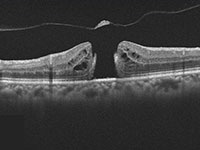

当院の眼科は、一般眼科から専門的な治療まで幅広い診療を行っていますが、特に網膜硝子体疾患については聖路加国際病院との連携のもとに専門的な治療を行っております。
当院眼科の副院長である大越貴志子は、網膜硝子体診療のエキスパートです。難治性網膜硝子体疾患にお悩みの方は、お気軽にご相談ください。
セカンドオピニオンを希望の際は紹介状を持参の上予約をお願いします。
● 診療内容
- 白内障手術
副院長である大越貴志子は白内障手術のエキスパートです。聖路加国際病院や他の施設と連携し、白内障手術を執刀します。多焦点眼内レンズなどのプレミアレンズも対応いたします。 - 網膜硝子体手術
副院長である大越は網膜硝子体手術のエキスパートです。黄斑前膜や黄斑円孔などの黄斑疾患の硝子体手術では定評があります。
黄斑前膜の手術適応についてのご相談も承ります。 - 硝子体注射
この度診療時間の拡充に伴い、当院では令和2年4月から硝子体注射を開始しました。
病院や診療所からの患者様のご紹介も受け入れ可能です。ご相談ください。 - マイクロパルス閾値下レーザー
マイクロパルス閾値下レーザーは、糖尿病黄斑浮腫や中心性漿液性脈絡網膜症を非侵襲的に治療する新しいタイプのレーザーです。当院の副院長の大越医師はマイクロパルス閾値下レーザーを我が国で初めて導入し、その治療は広く評価されております。
レーザー治療は、痛みがないのが特徴で、また、レーザー治療後に発生する網膜組織のダメージがほとんど起こらないのが特徴です。適応疾患は上記の疾患のほか、網膜静脈閉塞症、そして開放隅角緑内障(MLT)などです。従来のレーザーでは治療が不能と診断された方、また、硝子体注射が奏功しなかった、あるいは、再発を繰り返した方は、お気軽にご相談ください。
● 疾患別の治療
- 糖尿病網膜症
糖尿病黄斑浮腫糖尿病網膜症診療に欠かせないのが、レーザー光凝固術と硝子体注射、そして硝子体手術です。とくにレーザー光凝固術については、低侵襲レーザーである「マイクロパルス閾値下レーザー」を我が国で最初に導入し、その実績には定評があります。レーザーの侵襲を軽減したい方、あるいは硝子体注射で再発を繰り返しておられる方はお気軽にご相談ください。 - 中心性漿液性脈絡網膜症
多くの場合3か月程度で自然治癒する疾患ですが、遷延したり、再発を繰り返すと視力が低下したままになります。 レーザー治療にて網膜の下にたまった液を吸収されることが可能です。当院のマイクルパルス閾値下レーザーは、従来のレーザーでは治療が不能であった、中心窩付近に漏出点を有する症例でも非侵襲的に治療することが可能です。また、マイクロパルス閾値下レーザーは繰り返し行うことができますので、再発した場合もあきらめずに治療を継続することで、視力を維持することが可能となります。 - 加齢黄斑変性に対する硝子体注射
加齢黄斑変性の中でも滲出性加齢黄斑変性は早期に発見して硝子体注射を行うことで視力を維持または改善させる可能性が期待できます。この度診療日の拡充に伴い、当院では、令和2年4月から硝子体注射を開始します。診療所との連携にも対応します。お気軽にご相談ください。 - 網膜静脈閉塞症
黄斑浮腫が遷延することで視力が低下します。浮腫を速やかに消失させ、視力を改善、維持させるためには硝子体注射が極めて有効な治療です。お気軽にご相談ください。 - 緑内障
緑内障診療の基本は点眼薬です。ただし点眼薬でもコントロール困難な緑内障患者さんは少なくありません。そのような方に、最近では非侵襲的にレーザーにて房水の流出路を形成する治療が注目されています。当院ではマイクロパルスレーザー線維柱帯形成術(MLT)を導入しております。MLTはマイクロパルスレーザーを用い、非侵襲的に房水の流出を改善させる治療です。痛みは全くなく10分程度で終了します。MLTを希望される患者様はお気軽にご相談ください。 - その他の網膜疾患の診断と治療
網膜硝子体疾患のエキスパートならではの診断を行い、治療方針を提示することができます。お気軽に相談ください。
視力低下、目やに、目の充血やかゆみ、涙目、ドライアイ、眼精疲労、花粉症、飛蚊症、ものもらいなど眼に関わるどんな事でもお気軽にご相談下さい。
以下に疾患ごとにご説明致します。
【一般眼科】
|ドライアイ|コンタクトレンズによる眼の合併症|アレルギー性結膜炎(花粉症を含む)|白内障|
|緑内障|レーザー治療:レーザー線維柱体形成術 虹彩切開術 |飛蚊症 |子供の眼の病気 |
|まぶたと目の表面の病気 |
● ドライアイ
ドライアイとは、涙の蒸発量の増加や、分泌の減少、質の異常によって目の表面の健康が保てなくなる病気のひとつです。ドライアイは目の乾燥感、目の疲れ、異物感などのほか、涙や目やにが多くでる、光がまぶしい、視力は良いのになんとなく見にくいなど、様々な症状があります。最近は、パソコンやテレビ、携帯電話などの画面を見続ける生活により、まばたきが減り乾きやすくなることや、コンタクトレンズの長時間、長期間使用により、目の表面があれて涙の安定性が損なわれることなどが原因と考えられます。最近ドライアイの治療薬の選択の幅が広がり、これまで治らなかったドライアイが新しい点眼薬にて症状が軽くなるケースがあります。ドライアイの方は当クリニックにお気軽に御相談下さい。
● コンタクトレンズによる眼の合併症
コンタクトレンズを装用することにより、角膜の酸素不足が生じ、また免疫機転が働きにくくなることで、角膜に傷がついたり、感染症が発生しやすくなります。このような合併症を防ぐには、コンタクトレンズを正しく使用することが最も重要です。コンタクトレンズ装用中に痛み、充血を自覚した場合は速やかにに受診してください。なお、コンタクトレンズによる角膜炎や角膜潰瘍の中にはアカントアメーバなど、難治性で長期にわたって治療が必要なケースも少なくありません。重症化しないうちに速やかにレンズの装用を中止し、治療を開始しましょう。
● アレルギー性結膜炎(花粉症を含む)

アレルギー性結膜炎とは、花粉や住まいの中にあるほこり・ダニ等が原因になって起こる目のアレルギーのことをいいます。
最近では、住まいの中にあるほこりであるハウスダストによるアレルギーが急増しています。
花粉には季節性がありますが、ハウスダストは1年中室内にあるため、いつ病気になってもおかしくありません。
したがってこのアレルギーを「通年性(つうねんせい)アレルギー」と呼び、花粉症と区別しています。
結膜は外からの刺激や異物にさらされやすい組織で、涙などでいつもぬれています。
そのため、ハウスダストや花粉がくっつきやすく、アレルギーが起こりやすいのです。
● 白内障
白内障は目の老化現象で中高年の方の場合、ほとんどの方が発症します。
特に以下のような目の症状が出た場合、早めの受診をお勧め致します。
- かすんで見える
- 日常生活において、まぶしさを感じる
- 視力の低下 など
治療法としては白内障が進行していない場合には、点眼にて進行を予防し、経過観察を行うこととなります。
しかしながら日常生活に差し支えるような症状の場合には、手術により治療を行います。
≪ 白内障について詳しくはこちら ≫
● 緑内障
緑内障は、眼圧によって、眼球の後ろにある視神経が圧迫されて障害を起こし、視野が狭くなっていく病気です。
病気の進行をくい止めるために、眼圧を低くコントロールする事が最も有効とされています。
しかしながら、視神経は一度障害を受けると残念ながら回復しません。
緑内障は特に早期発見、早期治療が大切ですので、40歳になったら1度検査を受けることをお勧め致します。
≪ 緑内障について詳しくはこちら ≫
● レーザー治療:レーザー線維柱体形成術 虹彩切開術
房水の流出路を拡張する目的で従来からレーザー線維柱体形成術が行われてきました。近年、低侵襲レーザーにて房水流出路の改善を図る治療が登場しております。MLTはマイクロパルスレーザーにて非侵襲的に房水の流出路の改善を図る治療です。当院では点眼治療にて十分な眼圧低下が得られない患者様にMLTを施行しております。一方閉塞隅角緑内障では、瞳孔が広がった際に、隅角という房水の流出路が閉鎖し、眼圧が急激に上昇する疾患です。眼圧が上昇すると、霧視や頭痛、吐き気などの症状を来します。治療はすみやかにレーザーにて虹彩の根本に小さな穴をあけるレーザー虹彩切開術が適応になります。しかし、患者様の状態によっては白内障手術が適応になる場合があります。当院では患者様の社会的背景を考慮したうえ、患者様1人1人の意向を十分に聞きながら最適な治療法をアドバイスさせていただきます。
そして、迅速に高度医療機関をご紹介させていただきます。
● 飛蚊症
視界に糸くずや黒い影、蚊のようなものが見え、視点を変えるにつれ、それが動き回るように感じる症状があります。明るい場所で白いものや空を見た場合によく見え、多くの場合加齢により自然発生します。
飛蚊症自体は目の機能に問題はありませんが、網膜剥離の初期症状や糖尿病網膜症の症状として現れることもあります。特に網膜剥離の前兆としての飛蚊症では網膜裂孔が見つかる場合があり、速やかなレーザー治療が必要です。当院では網膜剥離のレーザー治療を行っております。まずはお気軽にご相談下さい。
● 子供の眼の病気
子供の眼は大人と異なり、眼の機能(はたらき)は未だ成長途上にあります。子供の眼の病気を早期に発見し適切に治療することにより、視力や視機能の成長が正常に発育し、正常な機能の眼をもつ大人に成長することが出来ます。子供における頻度の高い眼の病気は遠視や近視、乱視(屈折異常)、弱視、斜視、睫毛内反(逆さまつげ)、眼瞼下垂、霰粒腫、鼻涙管閉塞などがあります。
● まぶたと目の表面の病気
● 結膜弛緩症
白目の表面の薄い膜(結膜)がその下の層からはがれ、シワが出来る病気です。結膜弛緩症は、涙による目の表面のうるおいや正常な流れを邪魔して眼の様々な障害を引き起こします。「いつも涙っぽい」「ころころする」など多くの年配者の目の不快感の原因となっています。治療は、まず、うるおいを保たせるための点眼薬を処方します。症状が改善しない、重症な症例の場合は、弛んだ結膜の一部を切除する手術もあります。
● 涙道疾患
慢性の炎症などにより、眼と鼻をつなぐ涙道(るいどう)すなわち涙の排水管がつまり、涙があふれたり、目ヤニがたまったりすることがあります。いちど詰まるとなかなか改善しにくいですが、症状が軽いばあいは、涙道に器具をいれ、排水管を広げる治療を行います。しかし、つまったところに、細菌が感染し炎症をおこし、痛みを伴うような場合もあります。また、涙道に放線菌というカビの一種がはえて難治性の炎症をきたす場合があります。抗生物質の点眼、そして内服、そして、涙道の洗浄、など様々な治療が必要になります。
● 眼瞼疾患
眼瞼(まぶた)は眼球の損傷と乾燥を防止する役割をしています。
眼瞼疾患として一般的なのは、俗に「ものもらい」といわれているものがあります。この他、眼瞼疾患には多種多様のものがあり、角膜や網膜の疾患の様に視力に影響が及ぶ疾患は少ないのですが、少しでも眼の異常を感じたら、まずはお気軽にご相談下さい。
≪ 眼瞼疾患について詳しくはこちら ≫
|抗VEGF療法|光線力学的療法(PDT) |ピュアイエロー・レーザー光凝固装置 IQ577 |光干渉断層血管撮影機器(OCTA)|
|加齢黄斑変性症|糖尿病網膜症|裂孔原性網膜剥離 |黄斑前膜(黄斑上膜) |黄斑円孔|
|網膜静脈閉塞症 |中心性漿液性脈絡網膜症 |強度近視に関連する病気 |虹彩炎 ぶどう膜炎|
● 抗VEGF療法
脈絡膜新生血管の発育には、血管内皮細胞増殖因子(VEGF)が深く関わっています。
VEGFの働きを抑える「抗VEGF薬」を眼球内に注射して治療を行います。加齢黄斑変性症に対してはルセンティス・アイリーアが認可されています。硝子体注射は、点眼麻酔を行い、顕微鏡下にて抗VEGF薬を眼内に注入します。非常に細い針を用いますので、痛みはほとんどありません。当日は眼帯をせずに帰宅可能です。感染予防目的で前後に抗菌剤の点眼をしていただきます。十分に効果を発揮させるためには、注射を連続して受ける必要があります。通常は初回3か月間毎月注射し、その後は状態に応じて継続する、もしくは、投与間隔を延長してゆきます。加齢黄斑変性は、治療後の再発が多いため硝子体注射は長期間にわたって必要になることが多く、根気よく治療を受ける必要があります。
● 光線力学的療法(PDT)
ビスダインという新生血管に集まりやすい光感受性物質を静脈内投与し、薬剤を新生血管に取り込ませ、一定時間後に弱いレーザーを照射することで、網膜へのダメ―ジを抑えながら、新生血管を退縮させる治療です。2004年5月から日本での治療が開始されました。治療はPDT研究会が定めた資格を満たす認定医に限られています。高次医療機関と連携し治療します。加齢黄斑変性に対するPDTは初回治療として行うことはなく、抗VEGF治療との併用療法としての位置づけになります。
● ピュアイエロー・レーザー光凝固装置 IQ577

マイクロパルスモードによる侵襲の低い治療をお届けします。
マイクロパルスモードは、レーザー光の極短時間照射を可能にするモードです。
照射部位の熱の蓄積を抑制したレーザー照射は、網膜浮腫治療や緑内障治療に活用され、その実績を上げています。
◆ マイクロパルス閾値下凝固
網膜視細胞を破壊することなしに、網膜に出た浮腫の治療を行う治療方法です。
糖尿病黄斑浮腫、網膜静脈閉塞症の黄斑浮腫、そして、中心性漿液性脈絡網膜症が適応となります。
◆ マイクロパルス線維柱帯形成術(MLT)
房水の流れに重要な役割を果たす線維柱帯に瘢痕を残すことなく、眼圧を下げる緑内障治療です。解放隅角緑内障が適応となります。
● 光干渉断層血管撮影機器(OCTA)

網膜疾患や緑内障の診断に用いられてきた光干渉断層計(OCT:optical coherence tomography)は、非侵襲的に網膜の断面を描出する機器でとして広く普及しています。当院では、8年前からOCTを導入し、網膜疾患と緑内障の診断と治療に活用してきました。
今回、新たにOCTに血管撮影の機能が付いた光干渉断層血管撮影機器(OCTA: OCT angiography、アンギオOCT)を導入いたしました。
これまで、網膜の血管を描出するには造影剤が必要でした。しかし、この最新の機器を用いることにより、網膜やその下にある脈絡膜血管を、造影剤を用いずに短時間で血管撮影できるようになりました。造影剤を用いた検査(蛍光眼底撮影)は、手間のかかる検査であるだけではなく、副作用のリスクもあるため、実施できない患者様もおられました。 OCTAは、これまでの造影剤を用いた検査の問題点を解決してくれる画期的な機器です。
OCTAを用いることで、これまでの網膜の断層撮影に加えて
① 加齢黄斑変性の脈絡膜新生血管の描出や治療効果の確認
![]() |
![]() |
![]() |
| 治療前 | 治療後1か月 | OCTAで描出した 脈絡膜新生血管 |
パキコロイド新生血管症(PNV)に対するマイクロパルス閾値下レーザー治療を行い、網膜下液が吸収された症例。
② 糖尿病網膜症の早期診断と進展の評価
![]() |
![]() |
![]() |
| 糖尿病のない患者さんの 正常眼底 |
糖尿病患者で網膜症なしと 診断された方 |
単純網膜症 |
糖尿病患者さんでは眼底検査で所見がみられない時期にすでに血管の閉塞が始まっていることがわかります。このようにOCTAを用いることで糖尿病網膜症を早期にとらえることが可能です。
③ 網膜動脈閉塞症の診断
![]() |
![]() |
| 蛍光眼底撮影 | OCTAでは蛍光眼底撮影とほぼ一致した領域に 毛細血管の信号の低下がみられる。 |
④緑内障患者の視神経の血流評価
そのほか、様々な網膜疾患、黄斑疾患の診断と治療が可能となりました。
但し、疾患によって、従来の造影剤を用いた検査が必要な場合がありますので、医師と相談ください。
● 加齢黄斑変性症
加齢黄斑変性症は、網膜の中心窩にある黄斑部が老化により機能が低下するために起こります。
ものがゆがみ、中心部がぼやけてしまい、視界が狭くなります。
両方の目で見ると、あまり気にならないことがあるので、必ず片目ずつで確かめます。
特に50歳を過ぎた頃から見られ、高齢になるほど多くなる病気です。
「視力が良かったのに突然発病した」という気づく例が多くみられ、女性よりも男性の発症率が多いといわれています。
◆ 加齢黄斑変性の予防
禁煙がとても重要です。タバコを吸っているかた、そして、男性の場合、リスクが非常に高くなります。毎日の食生活も大切です。緑黄色野菜やミネラルの多い食物を十分に摂取しましょう。予防のためのサプリメントもあります。また、動物性の脂肪をさけ、なるべく魚を多く摂取しましょう。
● 糖尿病網膜症

先進国では糖尿病患者数が増加しております。我が国では50歳代から60歳代の糖尿病患者さんの38%が網膜症という眼の合併症に罹患しているといわれています。糖尿病網膜症に罹患すると最悪の場合、失明に至ります。
糖尿病網膜症は日本では現在、失明原因の第3位になっています。
糖尿病で受診しても内科だけで眼科を受診されない方がおられます。
糖尿病網膜症は自覚症状に乏しく、視力が良くても網膜症がおこっていることが少なくありません。
網膜症の発症は罹病期間、特に血糖コントロール不良期間と相関しています。副院長の大越貴志子は、糖尿病網膜症診療のエキスパートです。広尾羽澤内科眼科クリニックでは、糖尿病網膜症の診療に力を入れています。
◆ 糖尿病黄斑浮腫
糖尿病黄斑浮腫は糖尿病患者さんの視力低下の原因として最も注目されています。糖尿病黄斑浮腫は、糖尿病が原因で網膜の血管がこわれ、液体成分やたんぱく質、脂質などの成分が黄斑たまり、次第に視力が低下する病気です。黄斑浮腫の状態により薬物治療、レーザー治療、硝子体手術を単独または併用で行います。当院の大越医師は糖尿病浮腫治療に長年聖路加国際病院で取り組んできました。黄斑浮腫の状態により適切な治療をアドバイスすることが可能です。薬物治療の基本は抗VEGF硝子体注射です。初回1から3回導入期治療として施行し、その後症状に応じて注射を継続してゆきます。糖尿病黄斑浮腫に対する抗VEGF硝子体注射は、加齢黄斑変性と異なり、治療開始後2-3年経過すると注射の回数が次第に減少してきます。およそ5年程度かけてゆっくり症状を改善させてゆきます。治療の目標は黄斑浮腫によって恒久的に視力が低下することを防ぐことです。根気よく治療を継続しましょう。また症状に応じてステロイド局所療法も選択できます。
★マイクロパルス閾値下レーザー抗VEGF硝子体注射との併用療法
DMEに対する抗VEGF治療は、有効である反面、効果が十分ではない、あるいは、再発を繰り返す患者様は少なくありません。注射は高額ですので、なるべく注射の本数が減少することが望まれます。このような患者様に対し、マイクロパルス閾値下レーザー治療を併用する併用療法を当院では行っております。抗VEGF治療に抵抗する、あるいは再発を繰り返す患者様は、お気軽にご相談ください。また、レーザーにも硝子体注射にも抵抗する糖尿病黄斑浮腫患者様も少なくありません。このような患者様に対し、硝子体手術が有効であることがあります。当院の大越医師は硝子体手術のエキスパートです。硝子体手術は聖路加国際病院にて行っています。マイクロパルス閾値下レーザーとは大越医師が日本で初めて臨床導入した低侵襲レーザー治療で、糖尿病黄斑浮腫をはじめとしたさまざまな黄斑疾患に応用されています。
◆ 糖尿病網膜症のレーザー治療(光凝固)
糖尿病網膜症に対するレーザー治療は、網膜症の進行を阻止する目的で行う、汎網膜光凝固と、黄斑局所光凝固があります。汎網膜光凝固は、網膜の虚血領域をレーザーで破壊することで、網膜から硝子体の中に新生血管が発症し、出血や網膜剥離を引き起こすことを防ぐことが目的です。黄斑局所光凝固は、黄斑浮腫を抑える目的で行います。黄斑部の毛細血管瘤などの浮腫の原因となっている病巣部位を直接凝固したり、網膜色素上皮層を弱凝固することで、黄斑浮腫を引かせます。当院では前述したマイクロパルス閾値下レーザーを用いた低侵襲レーザー治療を行っております。お気軽にご相談ください。
◆ 増殖糖尿病網膜症に対する硝子体手術
レーザー治療を行ったにもかかわらず、あるいは、レーザー治療のタイミングを逃した結果進展し、網膜剥離や硝子体出血に至った患者様の場合でも硝子体手術を受けることで視力を回復させる可能性が期待できます。
糖尿病網膜症の早期発見のために定期検査の重要性
| 網膜症ステージ | 網膜症なし | 単純網膜症 | 増殖前網膜症 | 増殖網膜症 |
|---|---|---|---|---|
| 受診頻度 | 1年に1回 | 初期は1年に1回 中期以降は3-6か月に1回 |
状態により1-2か月に1回 | 状態により1-2か月に1回 |
糖尿病網膜症は早期発見ができれば、有効な治療を受けることが可能です。視機能の回復は難しいといわれますが、将来の失明予防のために重要な治療法です。糖尿病と診断されたことのある方、高血糖を健診で指摘された方は、定期的に眼科にて検査を受け、早期発見・早期治療をされることをおすすめいたします。
※糖尿病網膜症に対する痛みの少ない低侵襲レーザー治療
汎網膜光凝固術は、これまで、複数回の通院が必要で、痛みも伴う治療でした。近年パターンスキャンレーザーという、低侵襲レーザーが開発され、痛みが軽減されまた、複数回の通院が不要となりました。従来のレーザー治療を痛みで中断された患者様もパターンスキャンレーザーにて治療を継続することが可能です。お気軽にご相談ください。
● 裂孔原性網膜剥離
加齢により、硝子体が変化する、あるいは生まれつき、網膜が弱いために、網膜に穴があき、そこから、硝子体の液成分が網膜の下に入りこみ、網膜が色素上皮という後ろの膜から剥がれてくる病気です。網膜の裏の視細胞は、色素上皮細胞がないと生きてゆけないため、剥離を放置すると失明します。
初期の症状は飛蚊症といって虫、あるいは、輪のような、紐のようなものが飛んで見えるといった症状です。この時点では、網膜は剥離していないかもしれませんが、硝子体(眼の中の透明なゼリー状の物体)が網膜から剥離している可能性が高いです。その後しばらくすると、網膜に裂孔、すなわち裂け目が出来て、その時点から網膜剥離が始まります。ごく初期の網膜剥離はレーザー治療で治すことも可能です。しかし、進行した網膜剥離では、手術が必要です。
網膜剥離の可能性がある方は、速やかに当クリニックを受診して下さい。早期発見がとても重要です。
● 黄斑前膜(黄斑上膜)
黄斑とは、網膜の中心に位置し、視力の根源ともいえる組織です。黄斑前膜とは黄斑部の網膜の手前にセロファン状の膜を形成する病気です。はじめは自覚症状に乏しいのですが進行し、膜が厚くなると視力が低下し、また、膜が収 縮すると、歪みを自覚します。原因は解明されていませんが、加齢による硝子体という眼の中のゼリー状の物体が液体化し、そのことが原因で膜がはってくると考えられています。他に、炎症や強度近視眼、糖尿病網膜症、外傷や網膜剥離術後にも同様の膜形成をきたします。黄斑上膜の形態には個人差があり、みえにくさや視力の低下もひとそれぞれです。網膜の層構造が著しく乱れたり、黄斑部に偽円孔という、くぼみをきたすこともあります。
自然に膜がとれるケースがごくまれにみられますが、多くは、一度膜がはってしまうと、自然に治ることはありません。唯一の治療は硝子体手術です。膜を物理的に除去することで黄斑の形態を改善または維持することが可能です。
◆ 黄斑上膜の手術のタイミング
このように膜に個人差があり、手術のタイミングを決定することは、困難ですが、一般に自覚症状に乏しく視力が良好な時期は経過観察します。手術を検討するタイミングとしては、視力低下が進行した場合、ゆがみがひどくなった場合、運転などの生活に支障を来した時点です。OCTという網膜の断層撮影を定期的に行ってゆくと、網膜の外層という視細胞が集まっている層に乱れを生じてくることがあり、この所見が手術の時期を決定するのに参考になります。白内障と異なり、視力が極端に低下したり、ゆがみが極端にひどくなってから手術をしても、視機能の改善には限界があり、重症の黄斑上膜を長期間放置することは望ましいことではありません。当院の大越医師は硝子体手術のエキスパートで黄斑上膜の硝子体手術を多数行ってまいりました。手術は局所麻酔にて30から40分程度で終わります。手術は聖路加国際病院で行っております。黄斑上膜の手術を受けるかどうかお悩みの方は、お気軽にご相談ください。
● 黄斑円孔
黄斑に穴があくことにより視力が低下する病気です。真ん中がみずらい、他人の顔の中央がつぶれてみえる、などの症状をきたします。黄斑円孔はごく初期は自然に閉鎖する場合がまれにありますが、一般には進行し、放置すると円孔が拡大し視力低下が進行します。治療は硝子体手術になります。黄斑円孔の発生原因となっている眼の中のゼリー(硝子体)を切除し、孔の周囲の内境界膜という、網膜の表層の一部を剥離し(内境界膜剥離術)、最後に眼の中にガスを入れます。ガスの力で円孔が次第に閉鎖してゆきます。手術後は一定期間飛行機に乗ったり、気圧の低い所への移動はさけていただきます。
当院の大越医師は硝子体手術のエキスパートです。手術は聖路加国際病院で行っております。
◆ 網膜静脈閉塞症
網膜静脈閉塞症は、加齢や高血圧、高脂血症、糖尿病などにより網膜の血管がつまることで、その領域の網膜に出血をきたす病気です。自覚症状は、視界の半分が何となくみえにくい、まだらにみえる、歪んでみえるなどです。高血圧が主たる原因ですが最近では睡眠時無呼吸症候群が原因で起こることも分かってきました。視神経の中で血管が詰まると、網膜中心静脈閉塞症と呼ばれ、高度の視力低下に陥ることもあります。黄斑に水がたまると視力低下をきたします。閉塞の仕方により、虚血性と非虚血性に分類されます。静脈閉塞症の治療は近年抗VEGF療法が承認され、治療により多くの患者様で視力を改善または維持することが可能となりました。初回2か月から3か月程度連続して毎月抗VEGF薬の硝子体注射を行い、その後は必要に応じて治療を継続します。
虚血型といって、網膜の広範囲に血管の閉塞が認められる場合はレーザー治療も併用します。糖尿病黄斑浮腫ほどではないですが、一部の患者様で再発を繰り返す場合があり、その場合は当院ではマイクロパルス閾値下レーザーを行い、再発を抑えたり、注射の本数を減らす工夫を行っております。静脈分枝閉塞症の黄斑浮腫は、ほとんどの患者様で抗VEGF硝子体注射が有効ですが、重症度が患者様によって大きく異なり、1回の注射で軽快する方から、注射に抵抗する方もおられます。血管の閉塞した部位によっては自覚症状に乏しく硝子体出血や、血管新生緑内障などの合併症に陥るまで発見が遅れる場合があります。高血圧や高脂血症、睡眠時無呼吸症候群のある患者さんは、定期的に眼底検査を受けることを勧めます。
◆ 中心性漿液性脈絡網膜症
網膜の中心、すなわち黄斑部の後ろに水がたまる病気です。40歳代から50歳代にかけての働き盛りの男性に多い病気です。症状は中心がみづらい、中心の色が変わってみえる、歪んでみえる、などです。多くは自然に治り、3か月程の経過で視力も回復します。しかし、中心の見えにくさは残ります。しかし、長期間放置すると、視力低下が進み、回復困難になります。この場合は液が漏れている場所をレーザーで凝固する方法があります。通常のレーザーでは中心に見えにくい点(暗点)が残りますが、当院の大越医師は侵襲が少なく、暗点の出ない閾値下凝固を日本で初めて導入し、この疾患に対し、200例を超える多数の患者様の治療を行ってまいりました。漏出点(水漏れの箇所)が中心窩(網膜のものを見る一番中心)に近く、従来のレーザーでは治療が困難な患者様でも治療が可能です。また漏出点が明瞭でない症例や、パキコロイド新生血管といって中心窩下に新生血管を伴う方の治療も行っております。他院で治療が出来なかった方や、再発を繰り返している方は、お気軽のご相談下さい。この病気はストレスが原因と言われております。気晴らしをしたり、リラクセーションが必要です。
● 強度近視に関連する病気
近年、近視の解明が進み、強度近視眼においては、黄斑部にさまざまな形態変化を来すことが分かってきました。黄斑上膜、黄斑円孔のほか、近視性黄斑牽引症候群という、強度近視眼に特有の黄斑部の網膜が牽引により分離したり変形する病気があることが判明しております。このような疾患は最終的に網膜剥離に進展したり、恒久的な視力低下につながることが指摘されており、定期的に網膜の断層撮影(OCT)を行い、視力が高度に低下する前に硝子体手術を行うことが望ましいと考えられています。当院大越医師は近視性黄斑疾患に対する硝子体手術を多数執刀しております。また、近視性脈絡膜新生血管という、加齢黄斑変性に類似した脈絡膜に新生血管を来す疾患もあり、抗VEGF硝子体注射が適応になります。
近視が原因で視力が低下しているものと思っていたら、実は、このような重篤な黄斑疾患が隠れている場合があります。治療が手遅れにならないためには、強度近視の患者様は定期的な眼底検査を受けられることをお勧めします。お気軽にご相談ください。
◆ 虹彩炎 ぶどう膜炎
虹彩炎は「くろめ」の部分の虹彩という絞りにあたる部分の炎症です。多くは原因不明ですが、全身疾患の症状の一環として発症することがあります。症状は眩しい、充血、かすみ眼などです。さらに後ろの組織で網膜の外側のぶどう膜というところに炎症が起きた場合は、ぶどう膜炎と呼びます。眼の硝子体という、ゼリー状の物体が濁ってきたり、網膜に出血を起こすなど、多彩な変化をきたします。眼圧(眼の硬さ)が上昇し、視神経がやられ、高度の障害を残す場合もあります。治療は一般にステロイド系の点眼薬あるいは注射、内服薬や免疫抑制剤になりますが、原因となる全身疾患が判明した場合はそれに即した治療が選択されます。瞳が癒着しないようにするための散瞳剤も必要なことがあります。眼圧が高い場合は眼圧を下げる薬が必要です。重症のブドウ膜炎や原因不明のブドウ膜炎の場合は硝子体手術にて原因解明をかねた治療を行う場合があります。当院では聖路加国際病院と連携をとりながら、虹彩炎、ぶどう膜炎の治療を行っております。
広尾羽澤内科眼科クリニック
[ADDRESS] 東京都渋谷区広尾3-11-10
・広尾駅より徒歩10分
・恵比寿駅より徒歩12分
・東四丁目バス停より徒歩5分
■ 羽澤ガーデン正門跡前
[TEL] 03-6450-5160
診療科目(内科 眼科 循環器内科 呼吸器内科
糖尿病内科 アレルギー科 外科 往診応需)

※眼科外来担当医は月曜、火曜、木曜は大越医師、土曜は四方医師が担当します。
※眼科は受付時間の予約を承っております